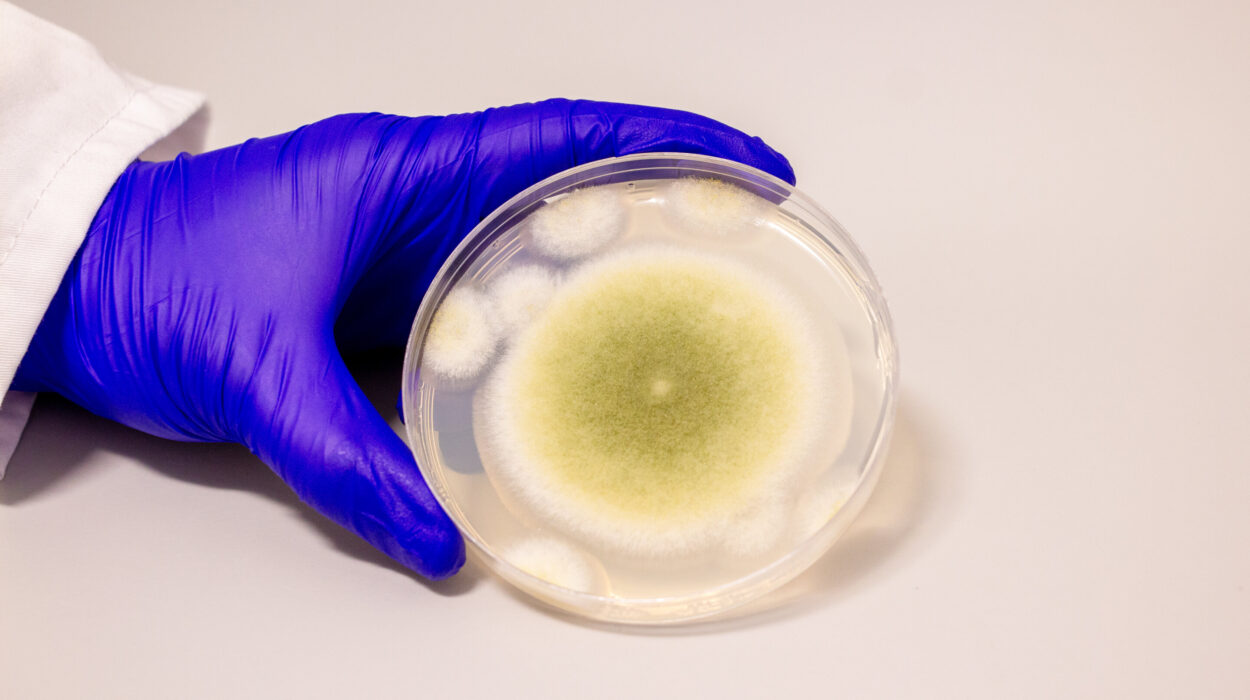

A new study published by Clarkson University’s research team provides fresh insight into an eco-friendly, plant-based alternative to the traditional chemical methods used to control Harmful Algal Blooms (HABs). The study explores the potential of using Moringa oleifera, a plant known for its numerous health benefits, to combat the cyanobacterium Microcystis aeruginosa, which is responsible for harmful algal blooms. This innovative research, led by Temitope Orimolade, Ngoc-Tram Le, and Lyle Trimble, has been featured on the cover of the scientific journal Soft Matter and is poised to alter our approach to combating one of the most serious environmental and public health challenges.
Harmful Algal Blooms and Their Environmental Threats
Harmful Algal Blooms (HABs) are explosive growths of algae that release potent toxins into the environment, often causing massive ecological and economic damage. These blooms, commonly caused by cyanobacteria like Microcystis aeruginosa, thrive in nutrient-rich water conditions often exacerbated by pollution from agricultural runoff or wastewater discharge. Cyanobacteria are notorious for releasing microcystins, a group of highly toxic compounds that pose severe health risks to humans, animals, and aquatic ecosystems.
Humans who come into contact with microcystins through recreational water activities may experience skin rashes or more serious health issues, including gastrointestinal distress, liver damage, or neurological complications. Pets, particularly dogs, are also vulnerable, with several reported cases of acute poisoning resulting from drinking contaminated water. Livestock can experience even more devastating effects, including sudden death.
Preventing the spread of HABs requires addressing the underlying issue—removing the harmful cyanobacteria before toxins can be released into the environment. Traditional methods for managing HABs often rely on chemical flocculants, like aluminum salts, to aggregate the cyanobacteria into clumps, making them easier to remove. However, these methods come with their own set of environmental drawbacks, such as the generation of toxic sludge, making alternatives a desirable research focus.
The Role of Moringa Oleifera in Water Treatment
Clarkson University’s recent study addresses this issue by proposing Moringa oleifera, a plant widely known for its nutritional and medicinal properties, as a natural, plant-based flocculant. The seeds of Moringa contain proteins that naturally promote the aggregation of particles in water, encouraging the cyanobacteria in harmful algal blooms to clump together—a process known as flocculation. The ability to remove these clumps efficiently from the water body holds promise as an effective way to mitigate the impact of HABs.
Unlike aluminum salts (commonly used flocculants like alum), which are highly effective but pose risks to the environment due to the formation of harmful sludge and potential contamination of water bodies with aluminum compounds, Moringa offers an eco-friendly alternative. The plant is biodegradable, non-toxic to humans, and potentially safe for aquatic life. Furthermore, Moringa seeds are already used as a food source in many parts of Asia and Africa, highlighting their established safety and low environmental impact.
Professor Sitaraman Krishnan, a leading figure in the research and a Professor of Chemical and Biomolecular Engineering at Clarkson University, noted, “While we have not yet fully explored the toxicity of Moringa extracts to aquatic life, the fact that it’s commonly consumed in parts of the world gives us confidence that it’s a safe, natural alternative. Our study seeks to explore how effectively Moringa can be used in a comparative context against traditional methods like alum.”
Insights from the Study: Comparing Moringa to Traditional Methods
In the study, Clarkson University’s researchers used Moringa oleifera extracts to treat Microcystis aeruginosa, comparing their results to the more commonly used aluminum salt flocculant—alum. They focused on critical factors such as the dosage required for effective flocculation, the strength and structure of the formed flocs, and overall comparative effectiveness in removing the harmful cyanobacteria.
The team’s findings revealed interesting differences in the way Moringa and alum performed under varying conditions. Alum, widely used in water treatment plants, works by neutralizing the charge of the particles in the water, allowing them to bind together into larger clumps, which can then be removed. Although effective, this process produces a toxic sludge, a byproduct containing soluble aluminum compounds, which can harm the aquatic environment.
In contrast, Moringa seed extracts appear to produce a slightly different pattern of flocculation. While the Microcystis cells aggregated well in the presence of both alum and Moringa, the floc structure formed by Moringa was distinctive, and the flocs were found to be less likely to break apart when subjected to natural water dynamics.
“In our study, we found intriguing differences between alum and Moringa oleifera in terms of the behavior of the flocs as they grew in size,” said Krishnan. “While alum created strong, larger flocs, Moringa produced smaller, more stable aggregates under certain conditions. These new insights will guide future research on how best to use Moringa for algae control and its long-term impact on water quality.”
Environmental Impact and Potential for Large-Scale Application
One of the most compelling reasons to explore the potential of Moringa oleifera as a plant-based flocculant is its environmental safety. While aluminum salts may leave lasting residues and pollutants in aquatic ecosystems, the use of Moringa could present a more sustainable solution. As a natural product, Moringa reduces the risk of harmful byproducts like toxic sludge, thus offering an environmentally friendly approach to HAB mitigation.
Despite these promising findings, there are still critical questions that need to be addressed. The research team notes that toxicity assessments to determine the effects of Moringa extracts on aquatic organisms are ongoing. Given that Moringa is widely used as food in human diets, it is assumed to pose minimal risk, but the broader ecological impact remains under study.
For example, additional research is needed to assess how the application of Moringa might influence aquatic life such as fish, amphibians, and invertebrates, and whether there could be unintended consequences from large-scale deployment in natural water systems.
“We have only begun to understand how Moringa can be used as an alternative flocculant in combating HABs,” added Krishnan. “Our research indicates that Moringa has a lot of potential, but more testing is required before it can be recommended for large-scale use in tackling harmful algal blooms.”
Future Directions and Real-World Applications
With growing concerns about the environmental impact of traditional chemical treatments, the search for sustainable and biodegradable alternatives is critical. The use of Moringa oleifera as a flocculant represents a small but promising step towards a cleaner, greener solution to water management challenges. Beyond combating HABs, Moringa could also be deployed in treating other forms of water pollution or used for water purification on a local or even industrial scale.
Additionally, global climate change is expected to exacerbate the occurrence and severity of harmful algal blooms, making research in sustainable water treatment methods all the more urgent. As Moringa’s use in water treatment continues to be explored, it holds the potential to transform how societies around the world deal with these environmental threats.
The Clarkson University team has shown that plant-based, sustainable solutions can offer an environmentally sound alternative to conventional methods. As new technologies evolve, these discoveries will no doubt play an integral role in tackling global water quality challenges, ensuring safer, healthier environments for future generations.
Conclusion
The innovative research from Clarkson University represents a significant contribution to the ongoing battle against Harmful Algal Blooms. By investigating the potential of Moringa oleifera as a biodegradable and environmentally friendly flocculant, the team offers a promising alternative to harmful chemical treatments, marking an important step towards more sustainable environmental practices. While more testing is needed, the study’s findings suggest that natural solutions to water pollution could play a vital role in safeguarding aquatic ecosystems and public health. In the ongoing struggle for cleaner water, Moringa’s potential could be a key weapon in the fight against harmful algal blooms.
Reference: Temitope Orimolade et al, Light scattering study of algal floc growth and structure: alum vs. polymeric plant-derived flocculant, Soft Matter (2024). DOI: 10.1039/D4SM00837E